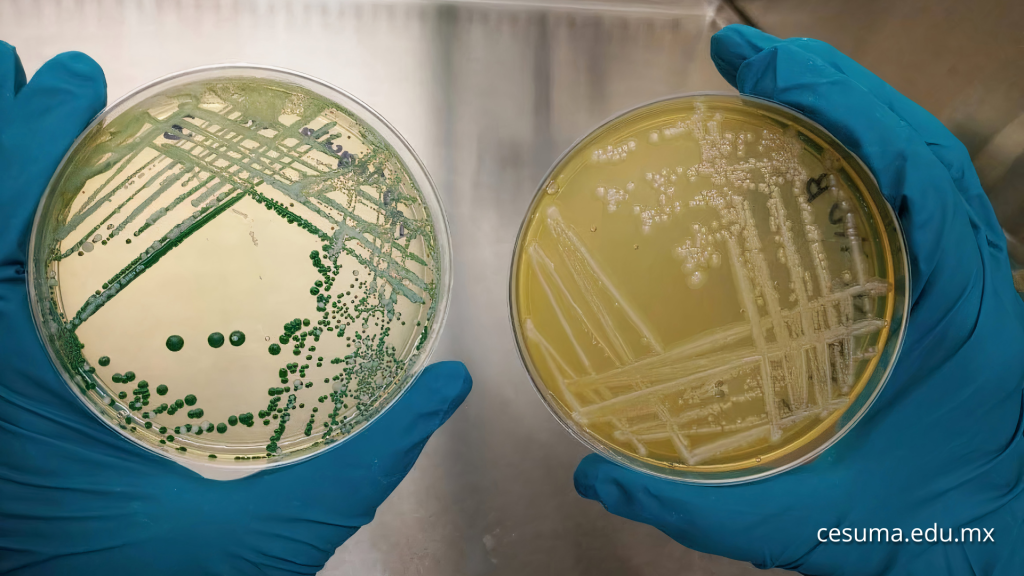

Detrás de cada alimento hay millones de microorganismos. Algunos nos nutren, otros nos enferman. Descubre cómo la microbiología alimentaria garantiza la seguridad de lo que comemos cada día.
¿Por qué hablar de microbiología en la comida?
La microbiología alimentaria estudia los microorganismos presentes en los alimentos: bacterias, virus, mohos y levaduras. Algunos son benéficos y esenciales en procesos como la fermentación. Otros, en cambio, son peligrosos, pues causan intoxicaciones y enfermedades transmitidas por alimentos (ETA).

Sin esta ciencia, no sabríamos por qué se descompone la leche, cómo fermentar el yogur ni cómo evitar la salmonela en un huevo. La microbiología de los alimentos es el corazón de la seguridad alimentaria, disciplina que protege la salud pública desde el campo hasta la mesa.
En la Maestría en Calidad y Seguridad Alimentaria de la Universidad CESUMA, aprenderás a aplicar esta ciencia en la industria, la investigación y la gestión de riesgos alimentarios.
¿Qué microorganismos viven en los alimentos?
Todo alimento alberga vida microscópica. Algunos microorganismos son deseables, otros contaminantes y unos pocos patógenos.
- Beneficiosos: como Lactobacillus o Bifidobacterium, se utilizan para elaborar yogures, quesos o encurtidos. Mejoran la digestión y fortalecen la microbiota intestinal.
- Alterantes: como Pseudomonas o Clostridium, provocan malos olores o sabores, aunque no siempre causan enfermedad.
- Patógenos: como Salmonella, Listeria monocytogenes o Escherichia coli O157:H7, sí representan un riesgo grave. Su presencia puede generar brotes epidémicos si no se controlan adecuadamente.
Identificar y controlar estos microorganismos exige técnicas de laboratorio, normas internacionales y una visión integral del sistema alimentario.
¿Cómo llegan los microorganismos a la comida?
El recorrido empieza en el entorno: el suelo, el agua, el aire y los propios manipuladores. Durante la cosecha, el transporte o el procesamiento, los alimentos pueden contaminarse. Las superficies, los utensilios y las malas prácticas de higiene son vías comunes de transmisión.
Por ejemplo:
- Un cuchillo mal lavado puede transferir bacterias de la carne cruda a las verduras.
- El agua no potable usada en el riego puede llevar E. coli a los cultivos.
- La falta de refrigeración acelera el crecimiento bacteriano en lácteos o pescados.
La microbiología permite comprender estos procesos y establecer puntos críticos de control (HACCP), fundamentales en toda empresa alimentaria certificada.
¿Qué hace la microbiología por la seguridad alimentaria?
El papel de la microbiología es doble: prevenir y detectar. En el laboratorio, los especialistas analizan muestras de alimentos, superficies y agua para identificar microorganismos dañinos. También estudian su comportamiento en distintas condiciones: temperatura, humedad, pH y oxígeno.
Gracias a esta información, se definen límites de seguridad y protocolos de higiene. La microbiología alimentaria es, por tanto, una ciencia aplicada a la salud pública, que permite reducir riesgos antes de que los productos lleguen al consumidor.
Un estudio de Frontiers in Microbiology destaca que el control microbiológico sistemático en la industria alimentaria reduce hasta en un 60 % los brotes de ETA. Puedes consultar el artículo completo aquí: Frontiers in Microbiology.
¿Qué métodos se usan para detectar microorganismos?
La ciencia ha avanzado enormemente en las últimas décadas. Hoy se combinan métodos tradicionales y técnicas moleculares:
- Cultivos selectivos: para aislar bacterias específicas.
- Pruebas bioquímicas: que identifican especies según su metabolismo.
- PCR (reacción en cadena de la polimerasa): para detectar material genético en pocas horas.
- Biotecnología e inmunoensayos: capaces de reconocer proteínas o toxinas bacterianas con precisión.
Estas herramientas permiten responder de forma rápida ante posibles contaminaciones, evitando la distribución de productos inseguros. Para conocer más sobre técnicas de detección microbiana, consulta el portal del Programa de Inocuidad Alimentaria de la FAO.
¿Qué factores favorecen el crecimiento microbiano?
Los microorganismos se desarrollan según cinco condiciones principales:
- Temperatura: la zona de riesgo va de 5°C a 60°C. Por eso la refrigeración es clave.
- Humedad: el agua libre facilita el crecimiento bacteriano.
- pH: los ambientes neutros (pH 6–7) son ideales para patógenos.
- Oxígeno: algunos microorganismos prosperan con oxígeno, otros sin él.
- Tiempo: cuanto más tiempo permanece un alimento en condiciones favorables, más riesgo existe.
Comprender estas variables ayuda a diseñar estrategias de conservación seguras, como el envasado al vacío, la pasteurización o la deshidratación. Puedes leer más sobre buenas prácticas de almacenamiento en la OMS.
¿Qué relación hay entre microbiología y calidad alimentaria?
La calidad alimentaria no se limita al sabor o la apariencia. También implica inocuidad, trazabilidad y control microbiológico. Un producto visualmente perfecto puede estar contaminado. Por eso, las empresas certificadas implementan sistemas integrados de gestión de calidad e inocuidad basados en normas internacionales como ISO 22000 o FSSC 22000.
El conocimiento microbiológico permite tomar decisiones técnicas y éticas: cuándo retirar un lote, cómo limpiar equipos o qué parámetros deben revisarse en el laboratorio. En este sentido, la microbiología se convierte en la columna vertebral de la confianza alimentaria.
¿Qué desafíos enfrenta la microbiología de los alimentos hoy?
Los nuevos desafíos surgen con los cambios en la producción global. El aumento del comercio internacional, el uso de empaques biodegradables y el cambio climático están modificando la ecología microbiana de los alimentos.
Aparecen cepas más resistentes, nuevas rutas de contaminación y microorganismos emergentes. Además, los consumidores exigen productos frescos, sin conservantes, lo que obliga a diseñar procesos más naturales pero igual de seguros.
La microbiología moderna debe anticiparse a estos retos con investigación, innovación y políticas preventivas. Puedes ampliar esta información en el Centro para el Control y la Prevención de Enfermedades (CDC).
Preguntas frecuentes sobre microbiología alimentaria
- ¿Todas las bacterias en los alimentos son malas?
No. Algunas bacterias son benéficas y se usan en la elaboración de productos fermentados como yogur, queso o pan. Lo importante es mantener el equilibrio y evitar las patógenas. - ¿Cómo puedo saber si un alimento está contaminado?
En muchos casos no se puede detectar a simple vista. Por eso existen normas de control microbiológico en la industria y se recomienda consumir productos certificados. - ¿Congelar los alimentos mata las bacterias?
No. La congelación detiene el crecimiento microbiano, pero no elimina todas las bacterias. Algunas pueden reactivarse al descongelarse el alimento. - ¿Qué diferencia hay entre pasteurización y esterilización?
La pasteurización reduce la carga microbiana sin eliminar todos los microorganismos, mientras que la esterilización busca destruirlos completamente mediante altas temperaturas o presión. - ¿Por qué son importantes los probióticos?
Los probióticos son microorganismos vivos que benefician la salud intestinal y fortalecen el sistema inmunológico. Se usan ampliamente en la industria alimentaria. - ¿Dónde puedo informarme más sobre seguridad alimentaria?
Fuentes confiables incluyen la EFSA, la FAO y la OMS.
Conclusión: la ciencia que garantiza lo que comemos
Cada alimento es un ecosistema vivo. Entenderlo es la base de una alimentación segura y sostenible. La microbiología de los alimentos revela lo que no se ve: el equilibrio entre vida, salud y tecnología.
Formarte en esta disciplina significa convertirte en guardián de la salud pública. Si te apasiona la ciencia, la inocuidad y el control de calidad, conoce la Maestría en Calidad y Seguridad Alimentaria de la Universidad CESUMA.
Este posgrado te capacita para liderar procesos de control microbiológico, diseñar políticas de inocuidad y garantizar que cada producto que llegue al consumidor sea seguro, nutritivo y confiable.





